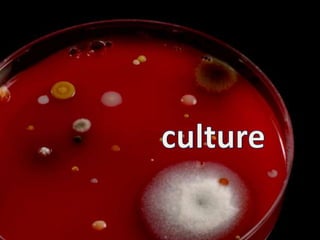
culture

Embed presentation
Download to read offline


































The document discusses how to effectively engage with customers and communities on social media. It introduces the "5 C's" framework of content, community, conversation, collaboration, and connections. It then provides practical tips for using social media to find and resolve complaints, track issues, promote campaigns, build communities, activate advocates, answer questions, and gather customer feedback. The document stresses the importance of overcoming potential barriers and having a plan to engage with customers on social media.